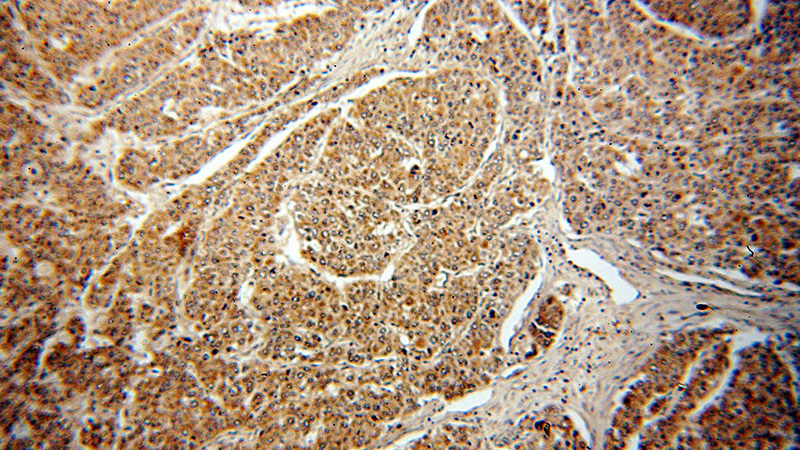
Immunohistochemical of paraffin-embedded human liver cancer using Catalog No:114427(RAB27B antibody) at dilution of 1:50 (under 10x lens)

-
Product Name
RAB27B antibody
- Documents
-
Description
RAB27B Rabbit Polyclonal antibody. Positive IHC detected in human liver cancer tissue, human breast cancer tissue, human prostate cancer tissue, human testis tissue. Positive WB detected in rat spleen tissue, A375 cells, DU 145 cells, MCF7 cells, PC-3 cells. Observed molecular weight by Western-blot: 25-30 kDa
-
Tested applications
ELISA, IHC, WB
-
Species reactivity
Human,Mouse,Rat; other species not tested.
-
Alternative names
C25KG antibody; RAB27B antibody; Ras related protein Rab 27B antibody
-
Isotype
Rabbit IgG
-
Preparation
This antibody was obtained by immunization of RAB27B recombinant protein (Accession Number: XM_005266733). Purification method: Antigen affinity purified.
-
Clonality
Polyclonal
-
Formulation
PBS with 0.02% sodium azide and 50% glycerol pH 7.3.
-
Storage instructions
Store at -20℃. DO NOT ALIQUOT
-
Applications
Recommended Dilution:
WB: 1:500-1:5000
IHC: 1:20-1:200
-
Validations

rat spleen tissue were subjected to SDS PAGE followed by western blot with Catalog No:114427(RAB27B Antibody) at dilution of 1:1000
Immunohistochemical of paraffin-embedded human liver cancer using Catalog No:114427(RAB27B antibody) at dilution of 1:50 (under 10x lens)

Immunohistochemical of paraffin-embedded human liver cancer using Catalog No:114427(RAB27B antibody) at dilution of 1:50 (under 40x lens)
-
Background
The Rab27 GTPase subfamily consists of two closely related homologs, Rab27a and Rab27b. Northern blot analysis revealed that Rab27b is expressed significantly only in testis, in which the predominant transcript was 1.4 kb in size. An 8-kb mRNA of unknown origin was detected in many tissues. Rab27b is associated with tubulovesicle membranes in the parietal cell and Rab27b may play a role in stimulation-associated membrane recruitment and gastric acid secretion. Rab27b is recently reported as a marker for breast cancer progression. It regulates invasive growth and metastasis in ER-positive breast cancer cell lines, and increased expression is associated with poor prognosis in humans.
-
References
- Shin SJ, Smith JA, Rezniczek GA. Unexpected gain of function for the scaffolding protein plectin due to mislocalization in pancreatic cancer. Proceedings of the National Academy of Sciences of the United States of America. 110(48):19414-9. 2013.
- Boelens MC, Wu TJ, Nabet BY. Exosome transfer from stromal to breast cancer cells regulates therapy resistance pathways. Cell. 159(3):499-513. 2014.
- Wang H, Wang Y, Bao Z. Hypomethylated Rab27b is a progression-associated prognostic biomarker of glioma regulating MMP-9 to promote invasion. Oncology reports. 34(3):1503-9. 2015.
- Zhang L, Zhang S, Yao J. Microenvironment-induced PTEN loss by exosomal microRNA primes brain metastasis outgrowth. Nature. 527(7576):100-4. 2015.
- Dong WW, Mou Q, Chen J, Cui JT, Li WM, Xiao WH. Differential expression of Rab27A/B correlates with clinical outcome in hepatocellular carcinoma. World journal of gastroenterology. 18(15):1806-13. 2012.
Related Products / Services
Please note: All products are "FOR RESEARCH USE ONLY AND ARE NOT INTENDED FOR DIAGNOSTIC OR THERAPEUTIC USE"
